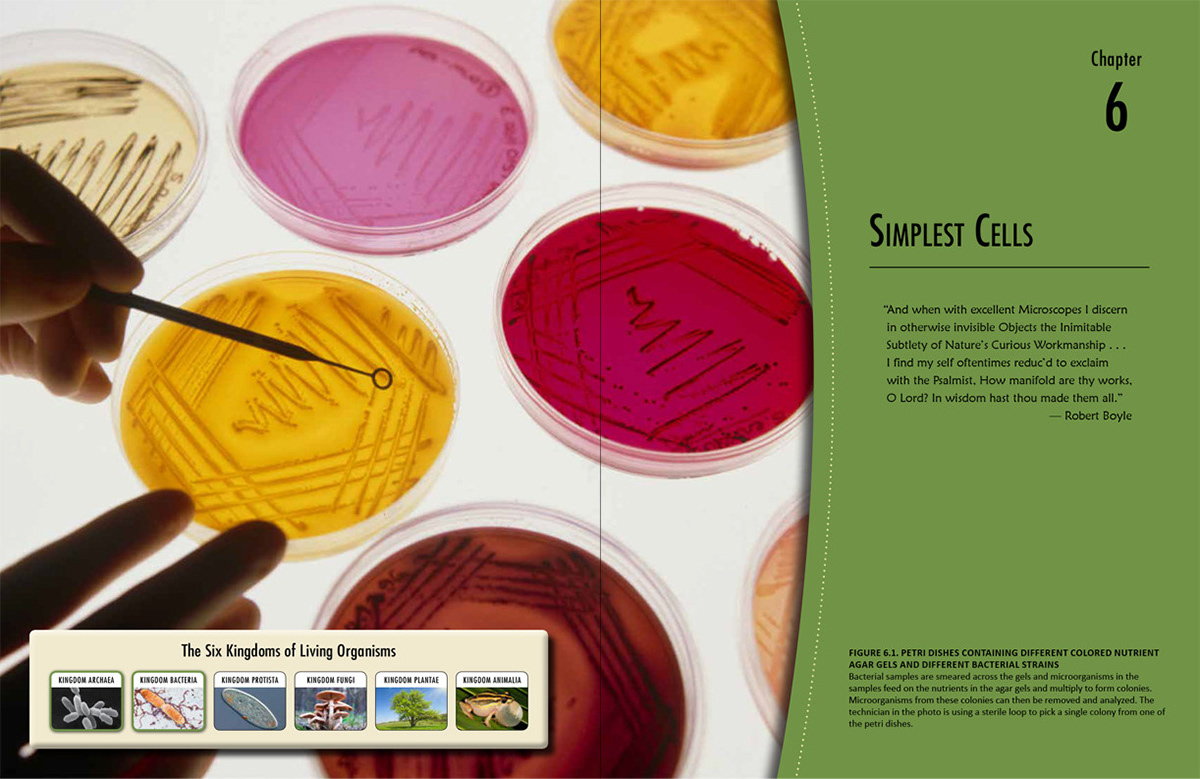

Downloadable Resources for Families
Civics at Home | downloadable resources for families
client: Edward M. Kennedy Institute
client: Edward M. Kennedy Institute

Leveled Readers and Teacher's Guides with Worksheets
ESL Extras | leveled readers and teacher's guides with worksheets
client: The Book Next Door (Australian publisher)
client: The Book Next Door (Australian publisher)

Leveled Student Readers and Teacher Guides
Lexia Close Reads | leveled student readers and teacher guides
client: Lexia Learning
client: Lexia Learning

Prototype Pages for Student Book, Workbook, and Teacher's Guide
Prototype Designs for an Islamic Studies Education Program
client: CubeStone Education
client: CubeStone Education

Life Science | science textbook for middle school students
client: Catholic Heritage Curricula
client: Catholic Heritage Curricula